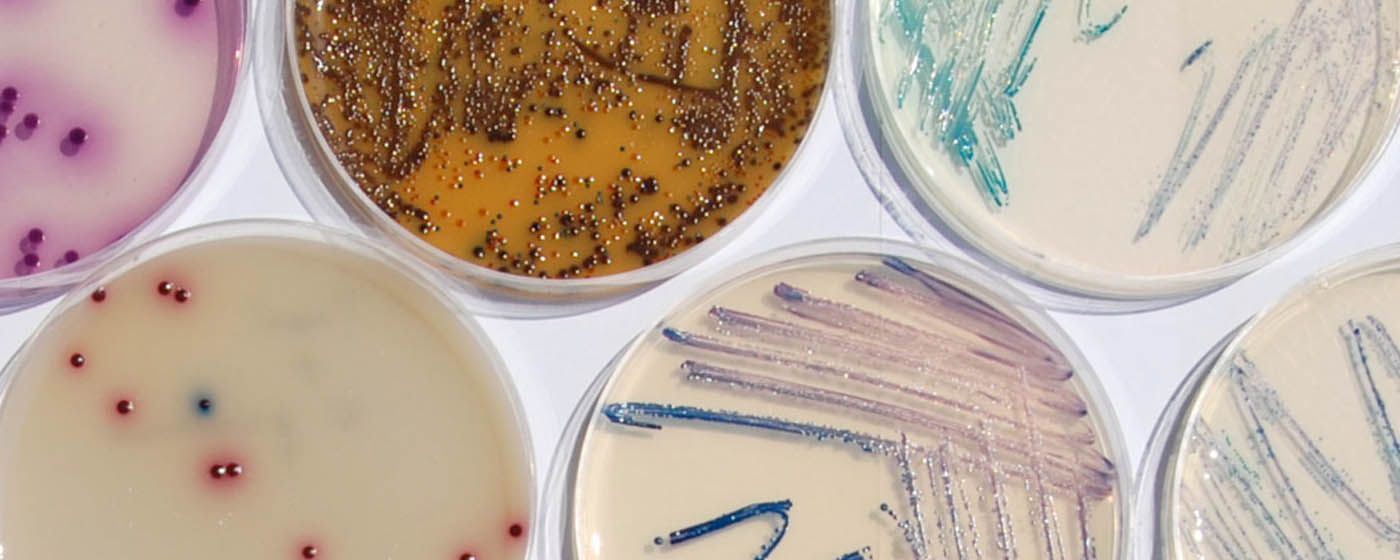
index.php?option=com_content&view=article&id=29067&catid=134&Itemid=845

Poznaj platynowego partnera Streamsoft - MDK SOFT
MDK Soft, od wielu lat pełniący rolę strategicznego partnera jednego z czołowych dostawców rozwiązań ERP - firmy Streamsoft, z powodzeniem utrzymuje status partnera platynowego, a także dynamicznie rozwija się, opierając swoją działalność na ścisłej współpracy i specjalizacji w branży produkcyjnej. Jak podkreśla Marek Kryszewski, właściciel MDK Soft, decyzja o nawiązaniu współpracy była efektem rosnących potrzeb klientów i dokładnej analizy dostępnych na rynku rozwiązań IT. Firma postawiła na ofertę, która zapewniła solidne fundamenty do rozwoju i dalszej ekspansji.
COO Sportano, Paweł Zwirecki: „Inwestycja w Streamsoft Verto to była bardzo dobra decyzja”
„Ten system ERP sprawdza się, jako kompleksowe i elastyczne rozwiązanie, które usprawnia zarządzanie całością kluczowych procesów w branży e-commerce i retail.”
Novita S.A. z systemem ERP Streamsoft Prestiż
Rozwiązanie Streamsoft całościowo optymalizuje kluczowe procesy, w tym kompleksowe zarządzanie produkcją, będąc kompletną odpowiedzią na potrzeby lidera branży włókienniczej.
Grupa RBB stawia na ciągły rozwój z systemem ERP Streamsoft Prestiż.
Rozwiązanie Streamsoft całościowo optymalizuje zarządzanie kluczowymi procesami, będąc kompletną odpowiedzią na potrzeby lidera branży metalowej.
R-GOL postawił na nowoczesny POS i skuteczny WMS od Streamsoft
Firma R-GOL działa na rynku od ponad 21 lat, jest jednym z liderów branży handlu nowoczesnego. Prowadzi e-commerce R-GOL.com, który jest największym piłkarskim sklepem internetowym w Polsce i jednym z największych w Europie. Posiada także sieć salonów stacjonarnych, w tym sklep w Warszawie o powierzchni 620m2! – to największy w Polsce i jeden z największych, jeżeli nie największy obecnie, piłkarski sklep detaliczny w Europie. R-GOL prowadzi także Oficjalny Sklep Kibica Reprezentacji Polski. W sumie w ofercie firmy jest ponad 8 tys. produktów piłkarskich, okołopiłkarskich i sportowych.
System ERP Streamsoft Prestiż w aplikacji na smartfon
Panel Managera, CRM DMS mobile, Aplikacja Kierownika Produkcji oraz Serwis mobile - to funkcjonalności systemu dostępne w aplikacji Streamsoft na Android oraz iOS.
Integracja z BaseLinker w Streamsoft Prestiż
Dostęp z poziomu systemu ERP do obsługi dowolnych systemów front-end oraz platform marketplace. To możliwe z integracją, którą zaproponowała firma Streamsoft.
System ERP skuteczny dla produkcji
Rozwiązanie informatyczne polskiej firmy Streamsoft, które na co dzień optymalizuje procesy w przedsiębiorstwach produkcyjnych różnych branż. Dopasowane jest do indywidualnych potrzeb klientów a skuteczność systemu ERP Streamsoft Prestiż w tym obszarze potwierdza ponad 350 wdrożeń oraz referencje.
Integracja z terminalami płatniczymi w systemach firmy Streamsoft
Funkcjonalność jest dostępna dla systemów Streamsoft PRO i Streamsoft Prestiż. Tym samym Streamsoft umożliwił firmom korzystającym ze swojego oprogramowania wykonanie i rozliczenie operacji z użyciem kart płatniczych bezpośrednio w systemie.
BioMaxima wybrała system ERP Streamsoft Prestiż
Branża biomedyczna cechuje się specyficznymi potrzebami w zakresie produkcji oraz musi przestrzegać restrykcyjnych norm w zakresie jakości. Wymogom tym, przy pełnej organizacji wszystkich procesów, z sukcesem sprostał system ERP Streamsoft Prestiż.
B2B Zamówienia Internetowe Streamsoft
To rozwiązanie online jest częścią rozwojowego portfolio aplikacji rozszerzających Streamsoft. Oferuje użytkownikom systemu ERP Streamsoft Prestiż możliwość zdalnej obsługi sieci sprzedaży w modelu B2B.
System ERP Streamsoft Prestiż w firmie RBB Stal
Oszczędność nakładów, zwiększenie wydajności, spójna i pełna kontrola nad procesami – to najważniejsze z korzyści jakie system ERP Streamsoft Prestiż zapewnia firmom z branży metalowej. Potwierdza to m.in. przedsiębiorstwo RBB Stal.
Streamsoft wprowadza aplikację Windykator
Ta kolejna propozycja firmy Streamsoft usprawniająca pracę z systemem ERP Streamsoft Prestiż. Aplikacja Widykator ma za zadanie zapewnić użytkownikom bieżącą i skoordynowaną kontrolę nad stanem należności firmy.
Sprawna realizacja wysyłki z aplikacją Kurier Streamsoft Prestiż
Jednym z czynników przesądzających o sukcesie w działalności firm jest sprawna obsługa wysyłek. Kompleksowość w tym zakresie zapewnia propozycja firmy Streamsoft.
Wielowymiarowa analiza danych z systemem Streamsoft PIVOT
Szybkie i przejrzyste dla użytkownika, a jednocześnie zaawansowane merytorycznie, analizowanie danych? To możliwe z nowym rozwiązaniem w systemie ERP Streamsoft Prestiż.
Integracja systemu ERP Streamsoft Prestiż z oprogramowaniem do nestingu
Eliminacja nadmiarowych zadań i oszczędności materiałowe – to podstawowe korzyści wynikające z integracji systemu ERP z programami do nestingu, którą Streamsoft Prestiż zapewnia w standardzie.
OPONEO wybrał system ERP Streamsoft Verto
Obsługa transakcji w modelu wielofirmowym i sprzedaż międzyspółkowa to kluczowe obszary za których sprawne funkcjonowanie w Grupie OPONEO.PL odpowiada system ERP Streamsoft Verto.
Lider branży handlu nowoczesnego R-GOL wybrał Streamsoft Verto
Omnichannel. Obsługa logistyczno-magazynowa, procesy sprzedaży i zaopatrzenia, rozliczenia finansowe. Streamsoft wdrożył w R-GOL system klasy ERP Streamsoft Verto, który odpowiada za realizację kluczowych procesów w firmie.
System ERP Streamsoft Prestiż w firmie farmaceutycznej IFOTAM Sp. z o. o.
Mechanizm kontroli przyjęć towaru i procesu zakupów, pełna ewidencja magazynowa czy automatyczne księgowanie dokumentacji – to niektóre z funkcjonalności systemu ERP Streamsoft Prestiż sprawdzające się w branży farmaceutycznej.
Techniczny koszt wytworzenia (TKW) w systemie ERP Streamsoft Prestiż
Ustalenie metody naliczania technicznego kosztu wytworzenia jest istotne w przedsiębiorstwie produkcyjnym każdej branży. W zależności od rodzaju działalności, kalkulacja różni się oczywiście składnikami i szczegółami. System ERP Streamsoft Prestiż wspiera wyliczenie TKW nawet w wymagających branżach, np. tworzyw sztucznych.